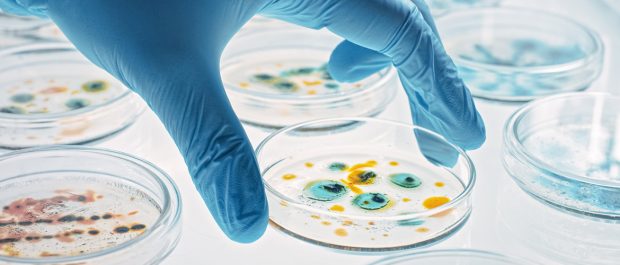

Antimicrobial Stewardship in Assisted Living: Protecting the Most Vulnerable
Antimicrobial Stewardship in Assisted Living: Protecting the Most Vulnerable Antibiotics, thought by some to be the greatest discovery of all time, extending human lifespan by decades, are facing a growing threat: antibiotic resistance. When bacteria develop resistance to these life-saving medications, infections become harder to treat. This leads to more severe illness, hospitalization, and even…